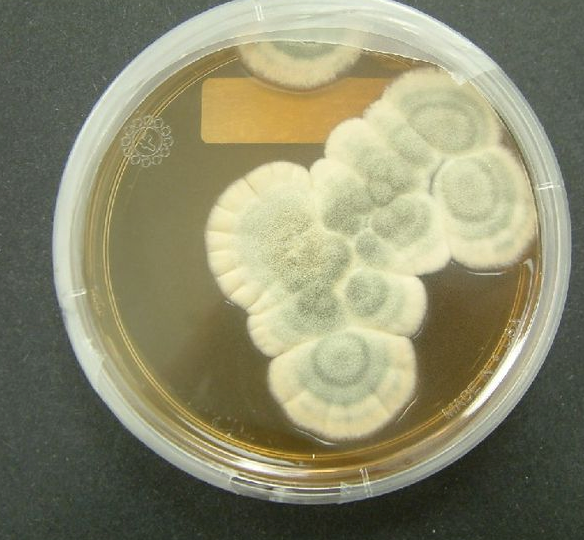

Les antibiotiques sauvent des vies
Les antibiotiques ont deux modes d’action différents:
1. Ils empêchent la croissance ou la multiplication des bactéries, sans tuer les bactéries proprement dites (= antibiotiques bactériostatiques)
2. Ils tuent les bactéries (= antibiotiques bactéricides)
Les antibiotiques agissent contre les bactéries sans affecter sensiblement les cellules humaines. En effet, ils attaquent en des points où les cellules bactériennes se différencient des cellules humaines. Ainsi les bactéries sont-elles les seuls organismes connus dont la paroi se compose de muréine. Ce sucre n’est présent que dans les bactéries. En outre, les bactéries ont d’autres ribosomes pour la fabrication des protéines et d’autres enzymes pour la réplication de l’ADN que l’être humain (voir chapitre 1, Génie génétique). Contrairement aux bactéries, les cellules humaines ne fabriquent pas non plus d’acide folique, l’être humain obtient celui-ci par l’alimentation. Les scientifiques ont utilisé toutes ces différences pour élaborer des substances actives qui nuisent uniquement aux bactéries, mais pas à l’être humain.
Mais il y a cependant un problème: des millions de bactéries vivent dans notre intestin et sont utiles à notre digestion. Or, les antibiotiques ne peuvent pas distinguer les «bonnes» bactéries de notre intestin des «mauvaises» bactéries qui nous rendent malades. C’est pourquoi un traitement par antibiotiques a tendance à déséquilibrer la flore intestinale et à entraîner des troubles digestifs. Mais ces effets secondaires s’estompent une fois le traitement par antibiotiques terminé.
Aussi efficaces qu’ils soient contre les bactéries, les antibiotiques sont en revanche complètement impuissants face aux maladies causées par des virus (par exemple la grippe ou le sida). Cela est dû au fait que les antibiotiques interviennent dans le métabolisme des bactéries. Les virus n’ont quant à eux pas de métabolisme propre. Pour leur reproduction, ils se servent d’une cellule hôte. Par conséquent, ils n’offrent aux antibiotiques pratiquement aucun point d’attaque.
© wikipedia